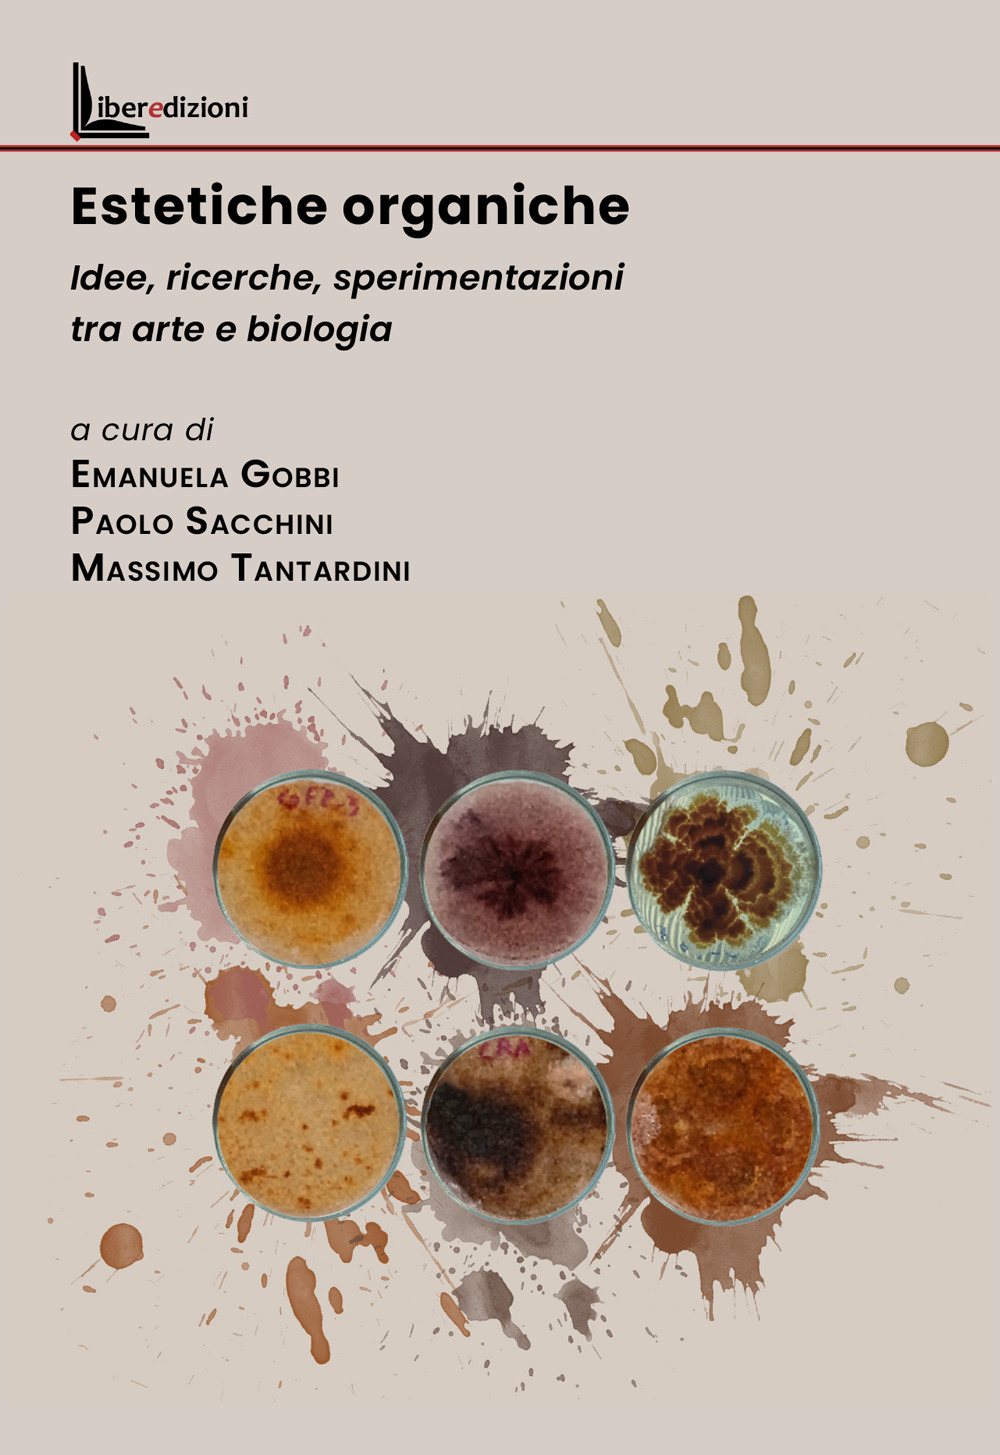
Estetiche organiche. Idee, ricerche, sperimentazioni tra arte e biologia

Categoria
Arte, Architettura e Design
Arte visiva, architettura, design e creatività.
118.556 libri trovati.

Disponibile
Arte e design
Estetiche organiche. Idee, ricerche, sperimentazioni tra arte e biologia
18,00 €


Disponibile
Arte e design
I luoghi che abiteremo. Rigenerazione urbana per l'innovazione culturale
10,00 €


Disponibile
Arte e design
Il racconto dell'architettura. Scrittura e narrazione nell'opera di Stefano Boeri
16,00 €

















